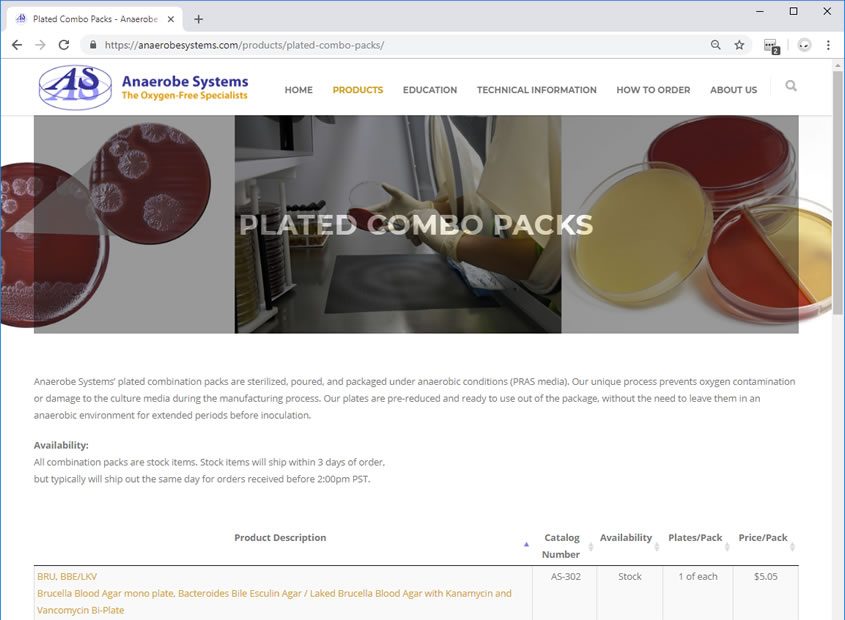

Anaerobe Systems
Anaerobe Systems was on an outdated CMS via Google Sites. The goal was to build a mobile friendly site, that allowed easy updates, and the transfer of all assets to the new hosting provider.
Client
Anaerobe Systems
15906 Concord Circle
Morgan Hill, CA 95037
Toll-free 800.443.3108
Telephone 408.782.7557
Our Task
Task
- Redesign site into WordPress platform
- Move all assets to new host/domain
- Custom Logo work (not implemented yet)
Skills Involved
Skills
-
- WordPress
-
- HTML, CSS
-
- Photoshop
Tag Cloud
Industry: Retail
Target: Morgan Hill Web Design